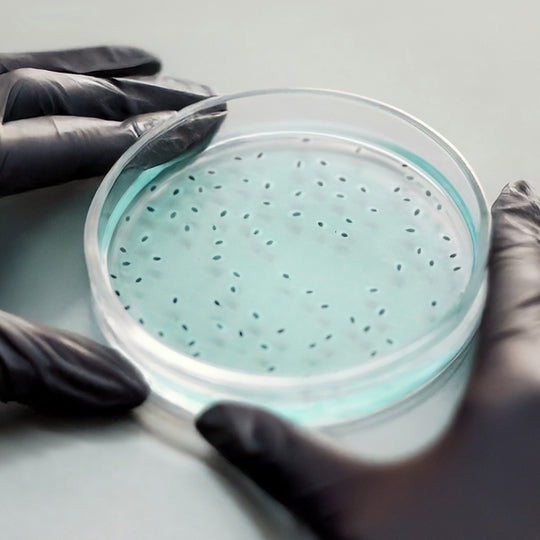

The Science Within Our Recipes
Plants, herbs, vitamins, minerals, and microbes are gifts of the Earth. Our scientific team bridges their wisdom with modern research to ensure each recipe is thoughtfully crafted, carefully dosed, and held to the highest standards of quality and integrity.
Ecosh Quality
Thorough, Trusted & Transparent

ISO 22000:2018 Certification
We follow the ISO 22000:2018 food safety standard to guide the way our supplements are crafted and handled. This certification is reviewed and renewed annually to ensure consistent quality and safety.
We follow the ISO 22000:2018 food safety standard to guide the way our supplements are crafted and handled. This certification is reviewed and renewed annually to ensure consistent quality and safety.

HACCP Principles
We apply Hazard Analysis and Critical Control Points (HACCP) principles to oversee every aspect of production, from raw ingredient sourcing and handling to the delivery of finished products. This allows us to stay ahead of potential risks and aligned with our commitment to safety and quality.
We apply Hazard Analysis and Critical Control Points (HACCP) principles to oversee every aspect of production, from raw ingredient sourcing and handling to the delivery of finished products. This allows us to stay ahead of potential risks and aligned with our commitment to safety and quality.

Production Technology Upgrades
We regularly update our equipment and production technology to help protect ingredient purity and maintain a clean, intentional and efficient crafting process.
We regularly update our equipment and production technology to help protect ingredient purity and maintain a clean, intentional and efficient crafting process.

Ongoing Team Training
Our team participates in ongoing training for food safety, hygiene, allergen awareness, microbiology, pathology, and quality standards to support consistency and care at every stage. These topics are woven into our daily conversations to ensure continuous improvement.
Our team participates in ongoing training for food safety, hygiene, allergen awareness, microbiology, pathology, and quality standards to support consistency and care at every stage. These topics are woven into our daily conversations to ensure continuous improvement.

Laboratory Tests and Analyses
We conduct routine laboratory testing to help monitor product quality and production cleanliness, working with specialists when needed to continuously improve our processes.
We conduct routine laboratory testing to help monitor product quality and production cleanliness, working with specialists when needed to continuously improve our processes.
-

ISO 22000:2018 Certification
We follow the ISO 22000:2018 food safety standard to guide the way our supplements are crafted and handled. This certification is reviewed and renewed annually to ensure consistent quality and safety.
-

HACCP Principles
We apply Hazard Analysis and Critical Control Points (HACCP) principles to oversee every aspect of production, from raw ingredient sourcing and handling to the delivery of finished products. This allows us to stay ahead of potential risks and aligned with our commitment to safety and quality.
-

Production Technology Upgrades
We regularly update our equipment and production technology to help protect ingredient purity and maintain a clean, intentional and efficient crafting process.
-

Ongoing Team Training
Our team participates in ongoing training for food safety, hygiene, allergen awareness, microbiology, pathology, and quality standards to support consistency and care at every stage. These topics are woven into our daily conversations to ensure continuous improvement.
-

Laboratory Tests and Analyses
We conduct routine laboratory testing to help monitor product quality and production cleanliness, working with specialists when needed to continuously improve our processes.
Ingredient Sourcing
A process of intention

Supplier Selection
We collaborate exclusively with suppliers who maintain recognized third-party certifications (including FSSC 22000, BRCGS, HALAL, KOSHER, FEMAS, and GMP+), participate in verified sustainability programs such as Friend of the Sea, and operate in compliance with applicable FSMA and FDA regulatory requirements.
We collaborate exclusively with suppliers who maintain recognized third-party certifications (including FSSC 22000, BRCGS, HALAL, KOSHER, FEMAS, and GMP+), participate in verified sustainability programs such as Friend of the Sea, and operate in compliance with applicable FSMA and FDA regulatory requirements.

Raw Material Testing
We work with established European intermediaries who test every batch in certified laboratories, providing full analysis certificates and quality guarantees.
We work with established European intermediaries who test every batch in certified laboratories, providing full analysis certificates and quality guarantees.

Quality Assurance
All ingredients are thoroughly inspected to meet the highest quality standards before being approved for production.
All ingredients are thoroughly inspected to meet the highest quality standards before being approved for production.

Branded Ingredients
When a recipe calls for specific branded ingredients, we establish trademark license agreements (TLA) with the manufacturers and incorporate their research and benefits into our products.
When a recipe calls for specific branded ingredients, we establish trademark license agreements (TLA) with the manufacturers and incorporate their research and benefits into our products.

Selection Criteria
Our priorities when selecting raw materials and suppliers, in order of importance, are: quality, reliability, price, and delivery consistency.
Our priorities when selecting raw materials and suppliers, in order of importance, are: quality, reliability, price, and delivery consistency.
-

Supplier Selection
We collaborate exclusively with suppliers who maintain recognized third-party certifications (including FSSC 22000, BRCGS, HALAL, KOSHER, FEMAS, and GMP+), participate in verified sustainability programs such as Friend of the Sea, and operate in compliance with applicable FSMA and FDA regulatory requirements.
-
Raw Material Testing
We work with established European intermediaries who test every batch in certified laboratories, providing full analysis certificates and quality guarantees.
-

Quality Assurance
All ingredients are thoroughly inspected to meet the highest quality standards before being approved for production.
-

Branded Ingredients
When a recipe calls for specific branded ingredients, we establish trademark license agreements (TLA) with the manufacturers and incorporate their research and benefits into our products.
-

Selection Criteria
Our priorities when selecting raw materials and suppliers, in order of importance, are: quality, reliability, price, and delivery consistency.
Certificates

Ecosh is devoted to sustaining the highest standards of supplement safety and quality, aligned with ISO 22000 and organic certifications, with FSSC 22000 certification underway.
ISO 22000 is a global standard for food safety management systems, setting universal requirements for all parts of the food supply chain, from producers to consumers. It encompasses principles of food safety management, risk analysis, communication, monitoring, and evaluation to ensure food safety throughout the production process. Ecosh obtained the certification on December 16, 2020, with annual renewals.
Ecosh’s organic certification, awarded on October 31, 2023, confirms that our production aligns with the European Union’s organic directives and Estonia’s organic laws. Ecosh's compliance with EU standards is recognizable by the mandatory EU organic logo.
We are in the process of implementing the FSSC 22000 (Food Safety System Certification) standard, a globally recognized food safety framework. Certification is targeted for completion in 2026.

Ecosh's Scientific Team
To us, every team member is equally important, regardless of their role. Yet it's our scientific minds, united by curiosity, precision, and purpose, who bring our mission to life. Our scientific team blends researchers, biochemists, nutritionists and experts from the pharmaceutical industry. Through their knowledge, dedication, and collaboration, they help shape the future of Ecosh's and modern, natural living.

Karl Kesküll
Laboratory Manager, R&D Specialist
With an MSc in Food Technology and Product Development, I focus on how nutritional compounds impact human health. At Ecosh, I work across laboratory analysis, quality assurance, and product development, helping create safe, evidence-based solutions rooted in science and tradition.

Karl Kesküll
Laboratory Manager, R&D Specialist
With an MSc in Food Technology and Product Development, I focus on how nutritional compounds impact human health. At Ecosh, I work across laboratory analysis, quality assurance, and product development, helping create safe, evidence-based solutions rooted in science and tradition.

Angelika Somelar
Head of Product Development
As Head of Product Development at Ecosh, I lead formulation strategy and the R&D team bringing our vision to life. My work blends plant pharmacology, functional bioactives, and holistic wellness to create clean formulas rooted in care, awareness, and good energy.

Angelika Somelar
Head of Product Development
As Head of Product Development at Ecosh, I lead formulation strategy and the R&D team bringing our vision to life. My work blends plant pharmacology, functional bioactives, and holistic wellness to create clean formulas rooted in care, awareness, and good energy.

Robert Kotsalainen
Quality Manager
My focus is food technology and product development, with experience in manufacturing and food safety systems. At Ecosh, I ensure GFSI compliance and support teams in delivering safe, high-quality products through close alignment, clear communication, and people-centered leadership.

Robert Kotsalainen
Quality Manager
My focus is food technology and product development, with experience in manufacturing and food safety systems. At Ecosh, I ensure GFSI compliance and support teams in delivering safe, high-quality products through close alignment, clear communication, and people-centered leadership.

Regina Ubaleht
Head of Production
As Head of Production at Ecosh, I oversee manufacturing processes to ensure each product is made with care, precision, and consistency. My focus is on high quality standards, smooth production flow, and strong alignment between production, quality, and product teams.

Regina Ubaleht
Head of Production
As Head of Production at Ecosh, I oversee manufacturing processes to ensure each product is made with care, precision, and consistency. My focus is on high quality standards, smooth production flow, and strong alignment between production, quality, and product teams.

Gätlin Trummar
Product Developer
With a background in physical education, I’m driven by how the mind and body work together. At Ecosh, I develop and refine evidence based, Nordic plant inspired formulas. I care deeply about creating meaningful support, guided by purity, honesty, and heartfelt care.

Gätlin Trummar
Product Developer
With a background in physical education, I’m driven by how the mind and body work together. At Ecosh, I develop and refine evidence based, Nordic plant inspired formulas. I care deeply about creating meaningful support, guided by purity, honesty, and heartfelt care.

Jaana Rästas
Purchase Manager
Sourcing clean and natural raw materials has been my passion for over 20 years in the food and health industry. At Ecosh, I focus on finding the right materials aligned with our R&D vision and quality standards, ensuring a stable and sustainable supply chain.

Jaana Rästas
Purchase Manager
Sourcing clean and natural raw materials has been my passion for over 20 years in the food and health industry. At Ecosh, I focus on finding the right materials aligned with our R&D vision and quality standards, ensuring a stable and sustainable supply chain.

Kaja Salus
Product Developer
My background is in pharmacy, with a strong interest in how ingredients work together in the body. At Ecosh, I contribute to product development and formulation refinement, guided by science, quality standards, and a caring, responsible approach. My focus is on creating well-tolerated solutions that support the body’s natural balance.

Kaja Salus
Product Developer
My background is in pharmacy, with a strong interest in how ingredients work together in the body. At Ecosh, I contribute to product development and formulation refinement, guided by science, quality standards, and a caring, responsible approach. My focus is on creating well-tolerated solutions that support the body’s natural balance.

Triin Boitsova
Purchase Specialist
At Ecosh, I oversee raw material purchasing and supplier relationships to ensure quality and consistency. Having previously worked with raw material blending, I understand how essential proper storage and handling are. For me, clarity, cleanliness, and the knowledge that every well-managed ingredient supports someone’s health are at the heart of my work.

Triin Boitsova
Purchase Specialist
At Ecosh, I oversee raw material purchasing and supplier relationships to ensure quality and consistency. Having previously worked with raw material blending, I understand how essential proper storage and handling are. For me, clarity, cleanliness, and the knowledge that every well-managed ingredient supports someone’s health are at the heart of my work.

Eva Liisa Oks
Liposomal Product Developer
At Ecosh, I develop liposomal and high-bioavailability formulas by combining food science, plant pharmacology, and holistic principles. I also collaborate with universities to advance research and create pure, effective solutions that support wellbeing.

Eva Liisa Oks
Liposomal Product Developer
At Ecosh, I develop liposomal and high-bioavailability formulas by combining food science, plant pharmacology, and holistic principles. I also collaborate with universities to advance research and create pure, effective solutions that support wellbeing.

Sirje Tooming
Product Knowledge Specialist
As Product Specialist I am supporting customers with questions about our products, their use, combinations, and quality. My approach is empathetic and always guided by individual needs. With a background in nutrition counseling and pharmacy, I help people make informed, body-aware choices that support natural balance and personal wellbeing.

Sirje Tooming
Product Knowledge Specialist
As Product Specialist I am supporting customers with questions about our products, their use, combinations, and quality. My approach is empathetic and always guided by individual needs. With a background in nutrition counseling and pharmacy, I help people make informed, body-aware choices that support natural balance and personal wellbeing.

Ecosh's Scientific Partners
Ecosh works closely with Tallinn University of Technology and the Institute of Biomedicine and Translational Medicine at the University of Tartu—both recognised in Estonia for their scientific research and development. By collaborating with local and global scientists and specialists, we uphold our research integrity, product quality, and ongoing innovation.
Didn't find answers to your questions about our quality assurance or scientific roots?
Discover Our Products
Customers' favorites
Award-winning supplements formulated with thoughtfully sourced, scientifically validated ingredients to support optimal absorption and function in your body.
















